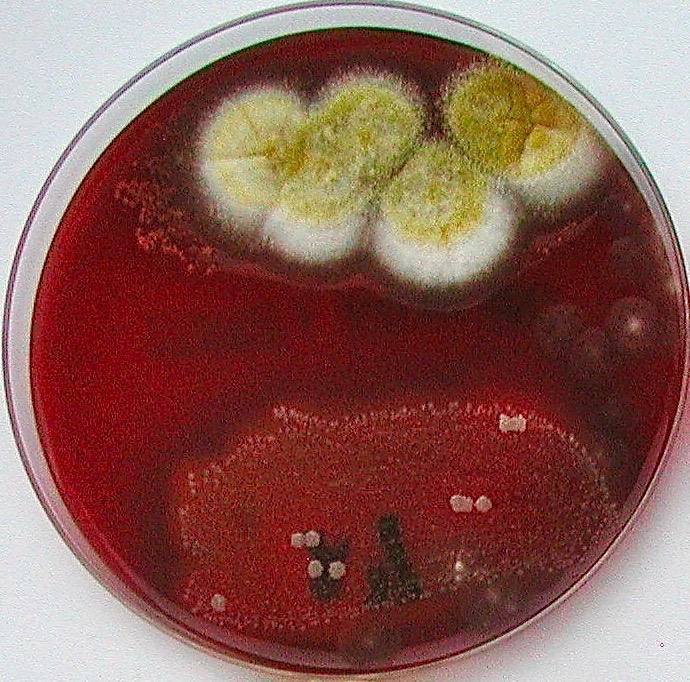

Mycologie médicale vétérinaire (hors dermatophytes et levures)
RECHERCHE D'AGENTS DE MYCOSE PAR CULTURE (hors dermatophytes et levures)

Intérêt : Diagnostic de mycoses cutanées ou profondes chez les animaux (Aspergillus, Scopulariopsis, Fusarium, Mucorales…)
Nature des échantillons : prélèvements biologiques (Écouvillons, cotylédons, LBA…)
Identification morphologique d'une espèce préalablement isolée sur gélose
Nature des échantillons : géloses (boîtes de Pétri, tubes en pente…)
ANALYSE MYCOLOGIQUE DE LAITS

Intérêt : Diagnostic de mammites fongiques et surveillance de la qualité mycologique du lait
Nature des échantillons :lait individuel, lait de mélange, lait de tank